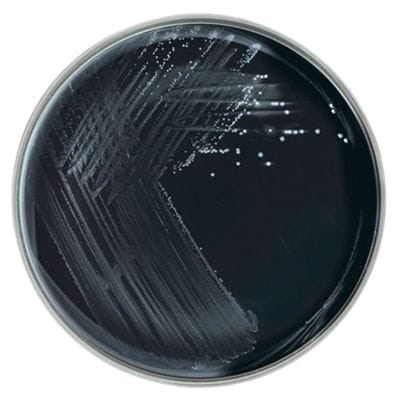
Campylobacter_Blood_Free_Selective_Agar_gotowa_pożywka_na_płytkach_Bestlabs.jpg

Campylobacter Blood Free Selective Agar (CCDA) gotowa pożywka na płytkach do izolacji Campylobacter spp.
• Opakowanie: 10 szt.
• Płytka: 90 mm.
• Do izolacji Campylobacter spp.
• Wyrób medyczny: Tak
 Opis
Opis
Campylobacter Blood Free Selective Agar (CCDA) – Gotowa pożywka na płytkach do izolacji Campylobacter spp.
Opis produktu
Campylobacter Blood Free Selective Agar (CCDA) to wysokiej jakości, gotowe do użycia podłoże mikrobiologiczne, opracowane z myślą o selektywnej izolacji bakterii Campylobacter spp.. Jest to produkt zgodny z nowoczesnymi wymaganiami laboratoriów diagnostycznych i analitycznych, umożliwiający precyzyjne wyniki w analizach klinicznych i próbkach żywności.
Dzięki innowacyjnej recepturze opartej na modyfikacjach Boltona, pożywka CCDA eliminuje potrzebę stosowania krwi, zastępując ją węglem drzewnym, siarczanem żelazawym i pirogronianem sodu, co zapewnia wyjątkową selektywność i niezawodność. Produkt dostępny w formie gotowych płytek o średnicy 90 mm, co znacznie usprawnia procesy laboratoryjne.
Główne cechy Campylobacter Blood Free Selective Agar (CCDA)
1. Selektywność i niezawodność
- Podłoże zostało opracowane specjalnie do izolacji Campylobacter spp., zapewniając wysoką selektywność dzięki zastosowaniu cefoperazonu jako środka selektywnego.
- Wyeliminowanie krwi z receptury zmniejsza ryzyko kontaminacji i uproszcza procedury diagnostyczne.
2. Innowacyjna formuła
- Zamiast krwi, podłoże zawiera węgiel drzewny, który pochłania toksyczne metabolity, sprzyjając wzrostowi bakterii Campylobacter spp..
- Siarczan żelazawy i pirogronian sodu wzmacniają właściwości wzrostowe, zapewniając optymalne warunki dla izolacji docelowych mikroorganizmów.
3. Wygoda i efektywność
- Gotowe płytki umożliwiają natychmiastowe wykorzystanie w laboratorium, eliminując potrzebę czasochłonnego przygotowywania podłoży.
- Standaryzowane formaty o średnicy 90 mm gwarantują spójność wyników i łatwość pracy.
Zastosowanie Campylobacter Blood Free Selective Agar (CCDA)
1. Diagnostyka kliniczna
Produkt znajduje zastosowanie w laboratoriach diagnostycznych, gdzie pozwala na skuteczne wykrywanie i izolację bakterii Campylobacter spp. z próbek klinicznych, takich jak wymazy kałowe.
2. Analiza żywności
Campylobacter spp. jest jednym z najczęstszych czynników powodujących zatrucia pokarmowe. Podłoże CCDA jest niezastąpione w badaniach mikrobiologicznych żywności, umożliwiając identyfikację tych patogenów w mięsie drobiowym, mleku i innych produktach spożywczych.
3. Badania środowiskowe
Podłoże stosowane jest również w analizach środowiskowych, umożliwiając wykrywanie bakterii Campylobacter spp. w wodzie, glebie i innych próbkach środowiskowych.
Dlaczego warto wybrać Campylobacter Blood Free Selective Agar (CCDA)?
Eliminacja krwi w recepturze
Dzięki zastosowaniu innowacyjnej receptury opartej na węglu drzewnym, siarczanie żelazawym i pirogronianie sodu, produkt oferuje wyjątkową selektywność i bezpieczeństwo użytkowania.
Wysoka selektywność
Cefoperazon jako środek selektywny skutecznie hamuje wzrost niepożądanych bakterii, zapewniając wiarygodność wyników.
Gotowość do użycia
Gotowe płytki skracają czas potrzebny na przygotowanie podłoża, co zwiększa efektywność pracy w laboratoriach mikrobiologicznych.
Wszechstronność zastosowań
Podłoże znajduje szerokie zastosowanie w diagnostyce klinicznej, analizie żywności i badaniach środowiskowych, co czyni je wszechstronnym narzędziem w mikrobiologii.
Specyfikacja produktu
- Opakowanie: 10 sztuk gotowych płytek.
- Średnica płytki: 90 mm.
- Zastosowanie: izolacja i wykrywanie bakterii Campylobacter spp..
- Formuła: zmodyfikowana receptura Boltona oparta na węglu drzewnym, siarczanie żelazawym i pirogronianie sodu.
Podsumowanie
Campylobacter Blood Free Selective Agar (CCDA) to zaawansowane, gotowe do użycia podłoże mikrobiologiczne, które zostało specjalnie opracowane do izolacji bakterii Campylobacter spp.. Dzięki innowacyjnej recepturze eliminującej krew i wysokiej selektywności, produkt spełnia najwyższe standardy laboratoriów diagnostycznych oraz przemysłowych.
__________________________________________________________________________________________________________________________________________________________________________________________
Jest to wyrób medyczny.
Wyrób medyczny przeznaczony wyłącznie do użytku profesjonalnego, zgodnie z definicją zawartą w art. 2 pkt 1.26 Ustawy o wyrobach medycznych. Produkty te nie są przeznaczone do stosowania w warunkach domowych. Zakupu mogą dokonać jedynie osoby posiadające Prawo Wykonywania Zawodu (PWZ) lub firmy, podając numer NIP podczas składania zamówienia. W przypadku zamówienia złożonego przez użytkownika domowego, zostanie ono anulowane, a ewentualna wpłata zwrócona na konto klienta.
__________________________________________________________________________________________________________________________________________________________________________________________
W powyższym linku znajdą Państwo bazę aktualnych certyfikatów firmy OXOID. Wystarczy wpisać numer LOT zamówionej przez Państwa partii, w celu uzyskania odpowiedniego certyfikatu.
 Koszty dostawy
Cena netto, nie zawiera podatku
Koszty dostawy
Cena netto, nie zawiera podatku
darmowa i wygodna wysyłka
już od 800 zł netto
Najwyższa jakość
produktów potwierdzona certyfikatami
Zakupy 24h na dobę
wygodne i bezpieczne
bezpłatna konsultacja
z ekspertem online